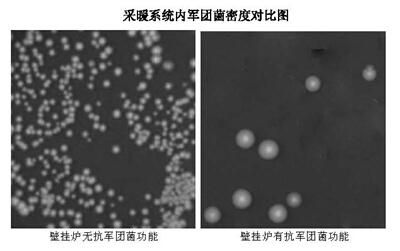

新冠病毒和非典外,还需防范军团菌肺炎危害
全民防范新型冠状病毒过程中,大家对新冠病毒肺炎和非典病毒肺炎都有了深入了解,但我们身边还有一个遍布全球且一年四季都可发生尤其冬季更容易高发的致命军团菌肺炎,你对它又了解多少呢。
军团菌肺炎顾名思义是由军团菌诱发的肺炎,其大量存在并快速繁殖于自来水管道、空调、采暖系统及淋浴器等温暖及潮热环境里,该细菌于1976年首次在美国费城某军营聚集性爆发,美国环保署研究表明:生活中,尤其冬季最常见的细菌之一就是军团菌,军团菌容易引发非常严重的、直至可以致命的肺炎,严重者可导致呼吸衰竭和肾衰竭,死亡率可达10-15%,如医疗介入不及时死亡率高达45%,在普通自来水中可存活400天以上,孕妇、发育中的婴儿、儿童、老人和其他脆弱群体等是军团菌易感人群。全球已经发生过50多次小规模疫情,在欧洲、美国、澳大利亚等国家和地区均有过流行,2015年纽约就曾因军团菌肺炎一次性致死7人,中国每年也有部分零散病例出现。
国研究机构也证实,多数军团菌感染均与冷热水管道系统、采暖系统、空调冷却水、淋浴水等有关。2015—2018年沈阳某小区采暖系统军团菌进行多次检测,军团菌检出率为40.6%。2018年对安阳市辖区内宾馆、酒店和商场、超市等35家公共场所的集中空调系统冷却水和冷凝水进行军团菌监测,10家检出军团菌,检出率为28.6%。

综上可见,军团菌肺炎虽然传染性与非典相当但没有新冠病毒传染性强,但其致死率却远远高于新冠肺炎和非典肺炎,居三者之冠,万万不可大意。
目前,全球都没有军团菌肺炎疫苗和特效治疗药物,那么怎么预防军团菌呢?专家给出以下方法和策略:
首先,从源头上防治军团菌,也就是选购设备时购买有抗军团菌或杀菌功能的采暖或空调设备,如意大利爱瑞卡壁挂炉,他们的抗军团菌功能能从根源上杜绝军团菌滋生和传播;下图为有无抗军团菌功能的区别。
其次,使用过程中进行有效预防,采暖或空调系统启用时,添加具有杀菌功能的保护剂,如拓沃采暖保护剂,其具有杀菌、防水垢、防腐蚀和防淤泥功能,同浓度下,其杀菌效果比84消毒液好与酒精不相上下,这不仅能杀死军团菌,还利于省钱,减少故障和延长设备寿命,可谓一举多得。
最后,培养良好的设备使用和防范习惯,如:经常检查采暖及空调系统,禁止跑冒滴漏;定期对系统内的循环水进行细菌消杀工作等等,也不失为前两个手段外的补救之策。
虽然在大自然面前,人类是渺小的,但无论是新冠病毒、非典病毒,还是军团菌肺炎,人类都逐步能防范和控制直至最终战胜它们。
网址:新冠病毒和非典外,还需防范军团菌肺炎危害 https://c.jiaju82.com/news-view-id-690272.html

